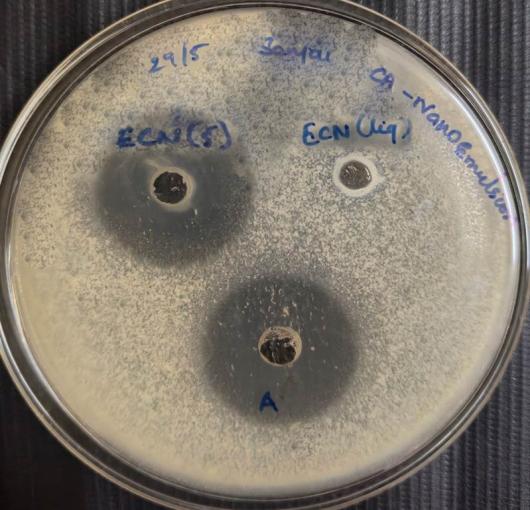
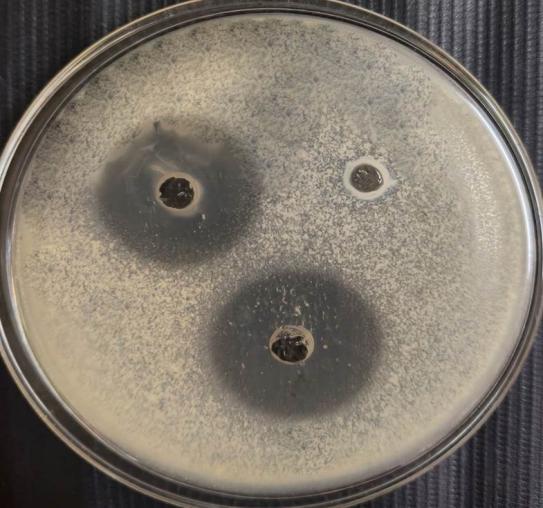

Department of Pharmaceutics, KLE College of Pharmacy, Bengaluru, Karnataka, India
*Corresponding author: Anasuya Patil; *Email: anusuya.raghu@gmail.com
Received: 06 Jul 2024, Revised and Accepted: 04 Dec 2024
ABSTRACT
Objective: The study aimed to use cold homogenization to create an Econazole Nitrate (ECN) nano-emulsion formulation.
Methods: Different ratios of surfactants (polypropylene 188 and Tween 80) and co-surfactants (ethanol) were used to create eight formulations. Out of them, compositions ECN1, ECN4, ECN5, and ECN7 were chosen due to initial research demonstrating encouraging outcomes. Dissolution studies evaluated droplet size, shape, drug content, and in vitro drug release characteristics. A comparative analysis was conducted to assess the improvement in medication release rates compared to pure drug formulations.
Results: ECN5, which attained an 89.43% drug release rate after 360 min, demonstrated the greatest medication release rate among the chosen formulations (ECN1, ECN4, ECN5, and ECN7). The improved formulations showed consistent spherical forms with droplet diameters ranging from 114 nm to 214.87 nm. Based on these findings, it appears that the nano-emulsion formulation successfully raises econazole nitrate's solubility, which is important because of its poor solubility in ocular administration applications.
Conclusion: The study used cold homogenization to effectively generate and optimize ECN nano-emulsion formulations. The most promising features of formulation ECN5, such as consistent droplet size distribution and dramatically improved drug release rates, were displayed. These results demonstrate the potential of nano-emulsions to enhance econazole nitrate's solubility and delivery effectiveness, especially for ocular applications.
Keywords: Econazole nitrate, Nanoemulsion, Anti-fungal activity, Ocular drug delivery, Drug release
© 2025 The Authors. Published by Innovare Academic Sciences Pvt Ltd. This is an open access article under the CC BY license (https://creativecommons.org/licenses/by/4.0/)
DOI: https://dx.doi.org/10.22159/ijap.2025v17i1.51756 Journal homepage: https://innovareacademics.in/journals/index.php/ijap
Fungal infections, including endemic mycoses, can present in different forms, varying from localized cutaneous infections to widespread infections. These diseases carry large risks of morbidity and mortality and they also play a significant strain on healthcare systems. The antifungal chemotherapy is necessary but it frequently shows only moderate activity against fungal cells and might cause relapses [1]. The patients need prolonged treatment for up to two years with medicines such as sulfonamides, polyenes, azoles, or echinocandins [2]. The increasing death rates, exacerbated by forms of infection that are resistant to antifungals, highlight the pressing need for new therapeutic targets. Fungal infections are hazardous for immunocompromised people, such as organ transplant recipients, intensive care unit patients, cancer patients, HIV-positive people, and chemotherapy patients. The increasing number of immunosuppressive instances has coincided with a rise in fungal resistance cases, which has complicated the effectiveness of treatment even more [3].
A topical treatment for several types of dermatomycosis brought on by dermatophytes and yeasts is econazole nitrate. It specifically targets dermatophytes that cause disorders like tinea pedis, tinea cruris, and tinea corporis, namely Trichophyton rubrum, Trichophyton mentagrophytes, and Trichophyton tonsurans. It also covers dermatomycosis brought on by yeasts such as Candida guilliermondii and Candida albicans [4]. ECN is available in multiple dose forms, such as skin cream (alone or in combination with triamcinolone), skin solution, skin lotion, and spray solution. This allows for flexibility in application, meeting the requirements and preferences of various patient populations. Its ability to effectively combat multiple fungal pathogens renders it a beneficial choice for managing dermatomycosis, offering respite, and aiding in the recuperation of afflicted persons [5].
The eye is a valuable organ that is frequently called a "window to the world," but it is also prone to several conditions that can cause visual loss. Numerous ocular drug delivery methods, including both conventional and novel techniques, have been developed to treat various disorders. Topical application is still the best way to treat eye problems, although drug absorption is hampered by the eye's defense systems, such as blinking and tear drainage [6]. The market is dominated by traditional eye remedies, including drops and ointments; however, they have poor therapeutic efficacy and quick drainage. In recent decades, innovative formulations such as liposomes, in-situ gels, nanoparticles, and ocular inserts have been developed to get around these restrictions [7].
The colloidal particulate systems, or nanoemulsions, are solid spheres with a lipophilic, amorphous surface and a negative charge that range in size from 10 to 1000 nm. They are effective drug transporters that maximize therapeutic benefits and reduce side effects. Treatments for RES infections, liver enzyme replacement therapy, cancer, and vaccinations are among the major uses. Emulsions can create nanoemulsions, which are thermodynamically unstable biphasic systems stabilized by emulsifiers. Because of their small size, nanoemulsions are transparent. There are three varieties of nanoemulsions: bi-continuous, water in oil, and oil in water. They promise accurate targeting and controlled release for a range of therapeutic approaches, providing diversity in drug delivery [8].
Numerous kinds of medications involve nanoparticles that are either in use or being developed. These consist of dendrimers, nanoshells, nanoemulsions (NE), nanosuspensions, nanospheres, nanocapsules, lipid nanoparticles, and nanotubes. With the help of an appropriate surfactant for stability, oil or water droplets are finely dispersed inside the opposing phase in nanoemulsions, which are defined by droplet sizes in the nanometer range [9]. The normal range of the droplet size is between 0.1 and 500 nm, depending on the surfactant composition, mechanical energy, and drug particles. Miniemulsions, sometimes referred to as submicron emulsions or nanoemulsions, are emulsions with an oil content typically ranging from 5% to 20% w/w. They can be water-in-oil (W/O) or oil-in-water (O/W) emulsions. Co-surfactant or co-solvent may be used to help improve drug solubilization when a combination of oils is used [10]. The aim of the work is to develop a drug delivery system with nano-scale characteristics which can improve the biopharmaceutical performance of drug.
Materials
Econazole nitrate was sourced from Yarrow Chemicals, Mumbai. Oleic acid was obtained from Nice Chemicals. Tween-80, ethanol, and sodium hydroxide were procured from SD Fine Chem Ltd, Mumbai. Poloxamer 188 was purchased from Strides Pharma Science Ltd, Bengaluru. Potassium dihydrogen orthophosphate was acquired from Molychem, Mumbai. For the fungal activity, Candida albicans, ATCC90028 and potato dextrose broth inoculated with the fungus were used in the cup plate.
Method
Preparation of Econazole nitrate Nanoemulsion
Oleic acid was used as the oil phase and Tween 80 and poloxamer 188 as surfactants to create an oil-in-water nano-emulsion. A 1:1 ratio of ethanol was employed as a co-surfactant. ECN was added to the oil phase. A clear emulsion was formed, water was added to the oil phase gradually, then poloxamer 188 and Tween 80 combined. Combining mechanical and chemical agitation techniques, the emulsion was stirred with a magnetic stirrer to create an oil-in-water nano-emulsion with smaller droplet sizes [11].
Saturation solubility
Examining ECN saturation solubility was crucial in the formulation experiments to determine which nanoemulsion components had the best solubilizing power. The solubility of ECN was evaluated with various oils, including vitamin E, olive oil, almond oil, coconut oil, Eucalyptus oil, and oleic acid. Approximately 5 mg of the ECN was added to screw-capped Greiner tubes containing 2 ml of each vehicle during the experiment. The liquids were extensively mixed with a vortex mixer for ten minutes to help the ECN to solubilize. The samples were shaken and then centrifuged for 15 min at 3000 rpm to precipitate the insoluble ECN. Parts of the supernatant were then removed for additional examination and characterization. This approach sought to determine which nanoemulsion component would be most useful for solubilizing [9-12].
FTIR-analysis
The Fourier Transform Infrared (FT-IR) spectra of ECN were acquired using a Jasco FT-IR spectrophotometer. The materials were first triturated and coarsely ground using potassium bromide (KBr), and then scanned between 400 and 4000 cm-1. Samples were compressed into a disc, put in a holder for measurement, and then exposed to KBr on a blank for FT-IR analysis. These spectra highlight particular functional groups, providing essential information on the molecular makeup of ECN and assisting in identifying those groups [13].
Construction of phase diagram
Phase diagram construction was made easier by the aqueous titration method and the CHEMIX program (version 11). T80 and poloxamer 188 were combined with ethanol as a co-surfactant to create a surfactant blend. Co-surfactant to surfactant weight ratios varied from 1:0 to 2:1. The "S mix" phase diagram was produced by adjusting the oil-to-surfactant mix ratios to identify phase boundaries. At each surfactant mix ratio, samples were obtained and visually evaluated for phase separation after the oil was gradually titrated into the aqueous phase. The phase diagrams that were produced showed clear zones that corresponded to various phases, offering insights into phase behavior under various circumstances [14].
Optimization
A two-level complete factorial setup was used in the experimental design to evaluate the impact of three formulation parameters on the physicochemical characteristics of the nanoemulsion. Oil content (A), Smix (B), and Homogenization speed (C) were the parameters that were examined. Each of these variables had two coded values (-1,+1). Based on this design, eight experimental runs were produced, with a randomized run order to guarantee statistical independence. Two copies of each formulation were made. The response variables of the nanoemulsions were ascertained, including droplet size zeta potential (ZP), and drug content. A first-order polynomial (factorial) model, which consists of coefficients multiplied by corresponding factor levels, was used to analyze the experimental data [15].
Droplet size, PDI, zeta potential
To assess ECN characteristics, the Malvern Zetasizer 4 (Nano ZS, Zen 3600; Malvern Instruments, Malvern, UK) was used. Zeta potential, polydispersity index (PDI), and average particle size were measured after injection water dilution [11]. The mean of three measurements is used to provide each value, which provides important information about the stability and uses of nanoparticles [16].
Drug content
In this assessment, the theoretical amount and the concentration of Econazole Nitrate (ECN) in each formulation were compared. After diluting each formulation in ethanol, centrifuging and filtering were done. Three repetitions of UV-Vis spectrophotometry at 225 nm were applied to analyze the final solution. Drug content was calculated as a percentage of the theoretical amount and denoted as "Drug Content-Confer 100." This was done by taking the mean and standard deviation of the data [16].
pH measurement
The pH of the sample was determined at room temperature using a calibrated pH meter (Sartorius, Germany). This systematic methodology guarantees accurate pH readings, improving comprehension of the acidity or alkalinity of the material [17].
Surface morphology
High-resolution imaging capabilities provided by SEM are essential for assessing different materials and identifying surface flaws, corrosion, impurities, and cracks [18]. Through interaction between atoms on the sample's surface and a concentrated stream of secondary electrons, SEM produces signals that offer comprehensive topographical information. Images are obtained at a 10,000-times magnification using the Nova NanoSEM NPEP system, displaying surface details with exceptional clarity. These photos' scale is calibrated to a 5-micrometer dimension scale, guaranteeing accurate surface structure assessment and analysis. [19].
In vitro diffusion study
In a drug release investigation, nanoemulsions loaded with ECN were examined using dialysis bags. Five mg of the drug samples were enclosed in separate dialysis bags, securely fastened, and immersed in pH-7.4 phosphate buffer solution, heated to 37±0.5 ⁰C. Agitation at 100 rpm ensured uniform dispersion of the samples. To maintain consistent conditions, 5 ml of released aliquots were withdrawn at set intervals and replaced with fresh buffer solution. The collected samples underwent triplicate analysis via UV-visible spectrophotometer at 225 nm wavelength, specific to econazole nitrate. Various release kinetic models were applied to the econazole nanoemulsion data. The model exhibiting the highest regression value (R2) was selected to characterize the release behavior. This rigorous methodology allows for understanding the controlled release of ECN, nanoemulsion, crucial for designing effective drug delivery systems.
Kinetic study
To study drug release from formulations, several kinetic models have been used, including first order, zero order, Higuchi, Korsmeyer-Peppas, and Hixson Crowell. The best fit was identified by the model with the greatest regression values. A thorough evaluation of the enhanced formulation's in vitro release kinetics was made possible by this methodical methodology. Researchers sought to comprehend the drug's behavior by analyzing the mechanisms and patterns of release over an extended period. Through in-depth analysis of formulation-environment interactions, important knowledge was acquired to improve drug delivery systems. The performance of the established formulation was made more effective and predictable by the use of many models, which guaranteed solid conclusions [20].
Ex vivo permeation study
Ex vivo goat corneas provide a useful model of the ocular membrane for research purposes regarding ocular medication distribution. Following the excision of the corneas, the tissue around them is carefully separated, and cold saline is used to cleanse them. The corneas are then immersed in a freshly prepared, 7.4 pH simulated tear fluid (STF) solution at low temperature. For the experiments, Franz diffusion cells are utilized. The corneas are positioned so that the corneal sidewalls and the formulation within the donor compartment are in close touch. A precise area of 0.785 cm2 is found to be available for diffusion over the cornea. Concurrently, STF is introduced into the receptor chamber, which is maintained at 34±0.5 °C, rotated at 50 rpm, and has its pH adjusted to 7.4. By creating a controlled environment that closely resembles physiological settings, this arrangement makes it possible to accurately quantify the amount of ocular medication that permeates the corneal membrane [21].
Anti-fungal activity
Growth conditions and fungal cultures Candida albicansATCC90028 were cultured for two to three days at 30 °C with 150 rpm of continuous shaking in a potato dextrose broth. Assay procedure: PDA (potato dextrose agar) medium inoculated with a fungal pathogen (1%) was poured into a sterile petri dish and allowed to harden. This is known as the Cup-plate method or the Well Diffusion Assay. Using a sterile cork borer, 4 mm wells were drilled and then inoculated with 100 μL of the provided sample (one loopfull of liquid was added to the well for the gel sample). To ensure adequate diffusion, the plates were left at room temperature for thirty minutes. Plates were then incubated for two to three days at 30 °C, and a zone of inhibition (mm in diameter) was noted. A positive control of the antibiotic fluconazole (1 mg/ml) was employed [22].
Solubility studies
Research on the saturation solubility of econazole nitrate seems to have been done using a range of oils, including vitamin E, oleic acid, coconut oil, castor oil, and olive oil. Among these oils, oleic acid demonstrated the maximum solubility of ECN, at approximately 3.04 mg/ml. Oleic acid was chosen to be the lipid phase in the manufacture of the ECN nano-emulsion. Its capacity to dissolve the greatest quantity of ECN, which makes it a good option for creating nano-emulsions with improved drug solubility, is probably the reason for this decision. The saturation solubility of ECN in the various oils studied is shown in fig. 1, with oleic acid exhibiting the highest solubility.

Fig. 1: Saturation solubility off ECN in various Oils. All data are represented as mean±SD (n = 3); where n is number of observations

Fig. 2: FT-IR spectrum of econazole nitrate, oleic acid tween-80, poloxamer 188, physical mixture and formulation ECN5
FTIR analysis
To confirm and authenticate the identity of ECN, the principal functional groups C=O, C-O, C-H, and C-C were identified. The corresponding peak wavelengths observed were 1655.59 cm-1, 1113.69 cm-1, 2931.27 cm-1, and 1591.95 cm-1, respectively. The drug's chemical composition was verified by ensuring that all primary peaks in the econazole nitrate sample fell within these expected ranges for its functional groups. This consistent profile supports the identity of the econazole nitrate sample. Similarly, for oleic acid, the functional groups C=O, O-H, and C=C were identified with observed wavelengths of 1714 cm-1, 2944.77 cm-1, and 720.28 cm-1, respectively. For Poloxamer and Tween 80, the functional groups identified included C-H and C-O. The observed wavelengths were 2968 cm-1 for Poloxamer, and for Tween 80, the functional groups were O-H, C-H, C=O, and C-O with observed wavelengths of 2359.48 cm-1, 2967.91 cm-1, 1743.33 cm-1, and 1277.61 cm-1, respectively. In the case of the physical mixture, functional groups C=O, C=C, and C-H were identified with observed wavelengths of 1584 cm-1, 1547 cm-1, 3108 cm-1, and 2968 cm-1. Finally, for the formulation ECN 5, the functional groups C=O, C=C, C-O, and C-H were identified with observed wavelengths of 1655.59 cm-1, 1113.69 cm-1, 2900.25 cm-1, and 1415.16 cm-1 as shown in fig. 2.
Construction of phase diagram
The goal of the pseudo-ternary phase diagram was to ascertain the ranges of concentrations for the oil, surfactant, and co-surfactant with an emphasis on formulation transparency and water uptake. Phase diagrams at surfactant to co-surfactant (S: COS) ratios of 5:4 and 3:7. Experiments revealed that stable nanoemulsions may be produced with as little as 5% oil. To ensure safety against toxicity and irritation, a minimum concentration of 45% of the S: COS mixture at a 6:4 or 1:9 ratio was chosen for stable nanoemulsions. Based on measurements of improved flux and permeability coefficients, the optimal water content of 50% was selected. The portion of the nanoemulsion mostly emerged towards the apex that was high in surfactants. With a high HLB value above 10 and good drug solubility, chromophore EL promoted stable O/W nanoemulsion production upon water diluting. Co-surfactants were required to achieve the temporary negative interfacial tension and flexible interfacial films necessary to generate nanoemulsions. The ratio of Smix greatly influenced the parameters of the nanoemulsion: COS mixture; larger concentrations of co-surfactant reduced the isotropic area and could cause the system to become unstable. Phase characteristics, such as the size and location of the nanoemulsion in the phase diagram, were significantly impacted by the mass ratio of surfactant to co-surfactant.


Fig. 3(a) Fig. 3(b)


Fig. 3(c) Fig. 3(d)
Fig. 3(a, b, c, d): Pseudo ternary diagram of ECN nanoemulsion, pseudo-ternary system diagram showing Oil in Water in nano-emulsion area at various Smix ratios and varying ratios of surfactants and co-surfactants. Smix ratios of a)5:5, b) 3:7, c) 1:9, and d) 6:4. As shown in fig. 3
Particle size
We analyzed diluted emulsions using the Malvern Instruments Nano-ZS equipment in Worcestershire, UK, to determine the mean droplet diameter and particle size distribution. A dependable predictor of mean particle size was found to be the Z-average diameter, which was obtained by applying the mie theory to data on signal intensity against particle diameter. Dilution was essential in reducing the impact of recurrent scattering events. To do this, samples were diluted 1:100 with pH 7.4 phosphate buffer without the use of cosolvents. This methodical methodology ensured accurate measurement of particle size parameters by enabling detailed characterization of emulsion droplets. We illuminated the subtle behavior of emulsion systems by delving into the fine features of particle dynamics through the application of dynamic light scattering techniques. The application Using Mie Theory improved the robustness of our findings and made it possible to extract useful data from measurements of signal intensity. This thorough approach allowed us to obtain important insights into the mean diameter and size distribution of emulsion droplets, which will serve as a strong basis for future research into these properties and their possible uses in a variety of industries, including cosmetics and pharmaceuticals. High amounts of surfactant formed rigid films covering the surface of oil droplets, maintaining sufficient distance between droplets. The droplets are spheric and nearly monodisperse by the data presented.

Fig. 4: Particle size of nanoemulsion ECN5

Fig. 5: 3D surface of particle size v/s concentration of oil and smix
Zeta potential
Zeta potential, which is obtained from electrophoretic mobility, is measured in micrometers per second by the Malvern Zetasizer Nano ZS90 test. Under some circumstances, particles with a zeta potential greater than or equal to+30 mV or less than-30 mV are regarded as stable. The strength of the repulsive or attractive forces between particles in a colloidal dispersion is reflected in this electrokineticcharacteristic. On the other hand, a very negative zeta potential indicates considerable interparticle repulsion, which also helps to stabilize the dispersion. Understanding and optimizing colloidal systems depends heavily on the measurement of zeta potential since it sheds light on the stability and behavior of dispersed particles. Researchers can customize formulas, modify processing parameters, and improve the performance of different colloidal suspensions in a variety of industries and applications, such as manufacturing and medicine. Zeta potential values in the nanoemulsion vary depending on the concentration of oleic acid present. Interactions between the functional groups of oleic acid and the other components in the nanoemulsion formula may be the cause of this difference. Observed similar results about the zeta potentials in nanoemulsions. Zeta potentials of blank and oleic acid-containing nanoemulsions were found to differ from one another. A zeta potential of nearly 30 mV ensures a high energy barrier toward the coalescence of dispersed droplets [23].

Fig. 6: Zeta potential of nanoemulsion ECN5

Fig. 7: 3D surface of Zeta potential v/s concentration on Smix and Homogenization speed
Table 1: Design matrix for ECN nanoemulsion
| Formulation code | Drug (mg) | Oil (ml) | Smix (ml) | Homogenization speed (rpm) | pH | Drug content |
| ECN1 | 10 | 12 | 15 | 2100 | 6.8±0.69 | 82.57±6.43 |
| ECN 2 | 10 | 10 | 12 | 2100 | 6.12±0.17 | 83.70±1.18 |
| ECN 3 | 10 | 10 | 12 | 1800 | 6.79±0.45 | 84.2±4.76 |
| ECN 4 | 10 | 12 | 15 | 1800 | 5.24±0.57 | 85.16±3.29 |
| ECN 5 | 10 | 10 | 15 | 2100 | 7.65±0.25 | 87.17±7.43 |
| ECN 6 | 10 | 12 | 12 | 2100 | 6.93±0.38 | 89.08±5.45 |
| ECN 7 | 10 | 10 | 15 | 1800 | 6.62±0.53 | 91.49±2.74 |
| ECN 8 | 10 | 12 | 12 | 1800 | 6.41±0.15 | 90.66±6.43 |
All data represented in mean±SD (n=3)
Drug content
A crucial component of pharmaceutical formulation is drug content analysis, which guarantees that the drug keeps its intended potency and quality throughout its shelf life. The study's conclusions show that, by US Pharmacopeia (USP) rules, the drug concentration was within the permitted range of 82-92% percent. This conformity to standards suggests that the active pharmaceutical ingredient (API) was not precipitated or degraded during the formulation process or storage conditions. It is important for pharmaceutical research to keep drug content within predetermined bounds for several reasons. First off, there is a direct correlation between it and the medication's therapeutic efficacy. By guaranteeing that patients receive the prescribed dose each time, consistency in drug content maximizes the intended therapeutic effects and reduces the possibility of under- or overdosing. Furthermore, it guarantees safety by averting possible negative consequences linked to irregular dosage. To ensure safety and efficacy, pharmaceutical products must adhere to strict regulatory standards, such as those established by the USP. Table 2 of the study presents a complete analysis of the drug content analysis data, offering valuable insights into the formulation process's precision and accuracy. Researchers and regulatory bodies can evaluate the integrity of the formulation processes used and the dependability of the data thanks to this openness in reporting. Reproducibility is further facilitated because other researchers can build upon or duplicate the findings with trust in the employed approach [23].

Fig. 8: 3D surface drug content v/s concentration on oil and homogenization speed
pH of nanoemulsion
Each nanoemulsion's pH stayed between the usual range of 5-7, reflecting the pH found naturally in the oral cavity. Maintaining pH within physiological ranges is essential to minimize potential discomfort and ensure compatibility with oral mucosa. Furthermore, the formulations' high percent transmittance results—which are almost 100%—indicate that they were transparent, clear, and capable of transmitting light effectively. This optical clarity reflects the homogeneity and stability of the nanoemulsions by showing a uniform dispersion of droplets inside them. In the section that follows, table 2 gives specifics about the % transmittance and pH measurements for every formulation, giving a thorough rundown of their optical and pH properties. These findings highlight the nanoemulsions' purity and appropriateness for oral administration, indicating both their potential efficacy and acceptability in applications related to medication and dental care.
Surface morphology
SEM analysis was performed on the optimized batch of nanoemulsion to evaluate its surface topography and shape. The findings showed a bicontinuous and hexagonal structure, which suggested that the constituents of the nanoemulsion were well-organized. The interconnected domains that make up this structural arrangement's hexagonal layout imply a steady and well-organized dispersion of the water and oil phases inside the surfactant matrix. The discovery of such a structure is noteworthy because it raises questions about the nanoemulsion's stability and suitability for a range of uses, including medicine delivery, cosmetics, and materials research. Optimizing the nanoemulsion'sperformance and customizing it for a certain application requires an understanding of its morphology [23].
The ideal ECN nano-emulsions are spherical, non-aggregated droplets that were verified by SEM data, which were compatible with earlier particle size assessment results that predicted nano-scale dimensions in fig. 9a and b.

Fig. 9(a) Fig. 9(b)
Fig. 9a and 9b: Scanning electron microscopy of nanoemulsion for ECN5
Factorial designs
The formulation design was improved using the Design Expert 13.0.0 version. The correlation between the variables (oil concentration, S mix concentration, and homogenization speed) and the responses (drug content, zeta potential, and droplet size) was determined. Response plots show the relationship between droplet size (DS), zeta potential (ZP), and drug content (DC) in reaction to changes in oil concentration, S mix concentration, and homogenization speed [24].
In vitro drug release study
In this work, a dialysis bag with a molecular weight cutoff (MWCO) of 2000 Da was used to assess the release of a drug-loaded nanoemulsion (NE). The dialysis bag was filled with a 0.5 ml sample of the NE. Using a beaker apparatus in a phosphate buffer (100 ml) dissolution media and the sample tied into the beaker the in vitro drug release was measured for one hour at 37±0.5 °C and 100 rpm. Five-milliliter aliquots were taken out of the release medium at preset intervals (0.5, 0.15, 1, 2, 3, 4, 5, and 6 h) [25]. Each sample was filtered after sampling, and the release jar was then filled with an equal volume of brand-new dissolving solution. The samples' drug concentrations were measured with a UV-visible spectrophotometer that was calibrated to 225 nm. The study of the drug release kinetics from the NE (nanoemulsion) at various time points is made possible by this analytical method. These evaluations are essential for comprehending the drug's solubility characteristics and their uses in controlled-release formulations. Regularly scheduled sample intervals and the restocking of dissolving media ensured accurate and consistent readings throughout the trial. These procedures reduce unpredictability and improve the accuracy of the collected data. Researchers can learn a great deal about how the NE formulation interacts with its surroundings to affect the pace and amount of drug release by tracking drug release over time. These kinds of insights are essential for forecasting the therapeutic efficiency of the drug delivery system and optimizing formulation parameters [26].

Fig. 10: In vitro release study of ECN 1 to ECN 8. All data are represented as mean±SD (n = 3); where n is number of observations
Kinetic study
In particular, the Korsmeyer-Peppas model and better formulation contribute to our understanding of in vitro drug release from nanoemulsion through the use of several kinetic models. Fitting to first order, zero order, Hixon-Crowell, and Korsmeyer-Peppas equations are shown graphically; the last exhibits remarkable accuracy. Release kinetics are compiled in table 2, which clarifies model performance. This thorough analysis clarifies complex drug release mechanisms from nanoemulsion formulations and provides valuable insights for improving pharmaceutical research and formulation design [27].
Table 2: Kinetic study
| Formulation | Kinetics models | ||||
| Zero-order | First order | Higuchi model | Korsemeyerpeppas model | Hixon-Crowell model | |
| ECN5 | 0.9805 | 0.9435 | 0.8925 | 0.9999 | 0.9560 |
Ex-vivo permeation study
This study used an automated diffusion cell sampling system (SFDC6, LOGAN Inst, NJ, USA) via goat skin in this study's ex-vivo permeation studies. The goat skin was put into a vertical diffusion sampling cell after it had been pre-treated, sliced, and trimmed to the proper size. Following the insertion of epidermal membrane samples, the diffusion cells were allowed to acclimate to 37±0.5 °C for 1-6 h. The skin's stratum corneum faced the drug giver cell in this configuration, with the dermal side facing the receptor phase. Acetate buffer with a pH 7.4 phosphate buffer was added to the donor and receptor compartments [28]. A Teflon-coated micro magnetic bar was used to stir the receptor fluid at 600 rpm, and the system was allowed to equilibrate for 8 to 10 h at 37±0.5 °C.0.5 ml aliquots were taken from the recipient cell at predetermined intervals (0, 1, 2, 3, 4, 5, and 6) for6 h following the application of the test formulation on the donor side. Following every collection, the removed volume was promptly replaced with an equivalent volume of new material that was kept at 37±0.5 °C. A 0.45μm membrane filter was used to filter and dilute the samples that were collected. Then, using a UV spectrophotometer set to 225 nm, the amount of medication in the receptor medium was measured. Ethanol was added to the pH 7.4 phosphate buffer to makemore soluble while maintaining sink conditions. This particular experimental design facilitated the examination of curcumin's penetration into the skin of goatsexvivoin regulated environments. Accurate and consistent measurements were maintained throughout the investigation by maintaining sink conditions, replacing withdrawn media with fresh buffer, and sampling at regular intervals [29].

Fig. 11: Ex-vivo permeation study compared with pure drug ECN vs ECN 5. All data are represented as mean±SD (n = 3); where n is number of observations
Anti-fungal activities
The antifungal activities of nanoemulsion for topical ocular administration against Candida albicans were assessed using the cup plate method. Candida albicans were cultured in potato dextrose broth at 30 °C with continuous shaking at 150 rpm for two to three days. Sterilized petri plates were pre-inoculated with 1% fungal pathogen, then potato dextrose agar medium was added and allowed to solidify [30]. 100 µl of the material was added to 4 mm wells that had been bored using a sterile cork borer. The plates were suitably diffused for thirty minutes at room temperature before being incubated at thirty degrees Celsius for two to three days, during which time the zones of inhibition were observed. The antibiotic ECN (1 mg/ml) was used as a positive control [31].
Table 3: Anti-fungal activity of nanoemulsion ECN5
| Sample | Zone of inhibition (mm in diameter) |
| Nano-emulsion-ECN5 | 22±3 |
| Pure drug | 18±1 |
| Antibiotic (fluconazole) | 22±2 |
All data are represented as mean±SD (n = 3); where n is number of observations

Fig. 12(a) Fig. 12(b)
Fig. 12: C. Albicans of formulation ECN5 and pure drug
The study's efficient creation and optimization of econazole nitrate nano-emulsion formulations involved cold homogenization. The formulation ECN5, with its uniform droplet size distribution and significantly increased drug release rates, demonstrated its most promising properties. These findings show that nano-emulsions have the potential to improve the solubility and efficiency of econazole nitrate administration, particularly for ocular applications. Further investigation into the efficacy and durability of these formulations in preclinical and clinical settings may be necessary to validate their potential therapeutic effects.
ECN – Econazole Nitrate, SEM – Scanning Electron Microscopy, mg – milli g, nm-nanometer, mm – milli meter, UV – Ultra Violet, Rpm – rotation per minute, HLB –Hydrophilic Lipophilic Balance
Nil
NK: The main investigator to do research, data collection and drafting of manuscript; AP: Proofreader, supervisor, approval of manuscript; HG: Perform statistical design and data interpretation
Declare none
Taborda CP, Uran ME, Nosanchuk JD, Travassos LR. Paracoccidioidomycosis: challenges in the development of a vaccine against an endemic mycosis in the Americas. Rev Inst Med Trop Sao Paulo. 2015;57 Suppl 19:21-4. doi: 10.1590/S0036-46652015000700005, PMID 26465365.
Hurtgen BJ, Hung CY, Ostroff GR, Levitz SM, Cole GT. Construction and evaluation of a novel recombinant T cell epitope based vaccine against coccidioidomycosis. Infect Immun. 2012;80(11):3960-74. doi: 10.1128/IAI.00566-12, PMID 22949556.
Medici NP, Del Poeta MD. New insights on the development of fungal vaccines: from immunity to recent challenges. Mem Inst Oswaldo Cruz. 2015;110(8):966-73. doi: 10.1590/0074-02760150335, PMID 26602871.
Wang Y, Wang C. Novel eye drop delivery systems: advance on formulation design strategies targeting anterior and posterior segments of the eye. Pharmaceutics. 2022;14(6):1150. doi: 10.3390/pharmaceutics14061150.
Nanjawade BK, Manvi FV, Manjappa AS. In situ forming hydrogels for sustained ophthalmic drug delivery. J Control Release. 2007;122(2):119-34. doi: 10.1016/j.jconrel.2007.07.009, PMID 17719120.
Modi D, Mohammad, Warsi MH, Garg V, Bhatia M, Kesharwani P. Formulation development optimization and in vitro assessment of thermoresponsive ophthalmic pluronic F127 chitosan in situ tacrolimus gel. J Biomater Sci Polym Ed. 2021;32(13):1678-702. doi: 10.1080/09205063.2021.1932359, PMID 34013840.
Shakeel F, Baboota S, Ahuja A, Ali J, Faisal MS, Shafiq S. Stability evaluation of celecoxib nanoemulsion containing tween 80. Thai J Pharm Sci. 2008;32(1):4-9. doi: 10.56808/3027-7922.2194.
Patel MR, Patel MH, Patel RB. Preparation and in vitro/ex vivo evaluation of nanoemulsion for transnasal delivery of paliperidone. Appl Nanosci. 2016;6(8):1095-104. doi: 10.1007/s13204-016-0527-x.
Shakeel F, Ramadan W. Transdermal delivery of anticancer drug caffeine from water in oil nanoemulsions. Colloids Surf B Biointerfaces. 2010;75(1):356-62. doi: 10.1016/j.colsurfb.2009.09.010, PMID 19783127.
Thomas L, Zakir F, Mirza MA, Anwer MK, Ahmad FJ, Iqbal Z. Development of curcumin loaded chitosan polymer based nanoemulsion gel: in vitro ex vivo evaluation and in vivo wound healing studies. Int J Biol Macromol. 2017 Aug;101:569-79. doi: 10.1016/j.ijbiomac.2017.03.066, PMID 28322948.
Tarik Alhamdany A, Saeed AM, Alaayedi M. Nanoemulsion and solid nanoemulsion for improving oral delivery of a breast cancer drug: formulation evaluation and a comparison study. Saudi Pharm J. 2021;29(11):1278-88. doi: 10.1016/j.jsps.2021.09.016, PMID 34819790.
Ali HH, Hussein AA. Oral nanoemulsions of candesartan cilexetil: formulation characterization and in vitro drug release studies. AAPS Open. 2017;3:3-16. doi: 10.1016/j.ijpharm.2013.10.044.
Shafiq-un-Nabi S, Shakeel F, Talegaonkar S, Ali J, Baboota S, Ahuja A. Formulation development and optimization using nanoemulsion technique: a technical note. AAPS Pharm Sci Tech. 2007 Apr 6;8(2):28. doi: 10.1208/pt0802028, PMID 17622106.
Mehrandish S, Mirzaeei S. A review on ocular novel drug delivery systems of antifungal drugs: functional evaluation and comparison of conventional and novel dosage forms. Adv Pharm Bull. 2021;11(1):28-38. doi: 10.34172/apb.2021.003, PMID 33747850.
Kommuru TR, Gurley B, Khan MA, Reddy IK. Self emulsifying drug delivery systems (SEDDS) of coenzyme Q10: formulation development and bioavailability assessment. Int J Pharm. 2001;212(2):233-46. doi: 10.1016/s0378-5173(00)00614-1, PMID 11165081.
Lawrence MJ. Surfactant systems (SEDDS): microemulsions and vehicles as vehicles for drug delivery. Eur J Drug Metab Pharmacokinet. 1994;19(3):2257-69. doi: 10.1016/j.jddst.2021.103047.
Kalam MA, Alshamsan A, Aljuffali IA, Mishra AK, Sultana Y. Delivery of gatifloxacin using microemulsion as vehicle: formulation evaluation transcorneal permeation and aqueous humor drug determination. Drug Deliv. 2016;23(3):896-907. doi: 10.3109/10717544.2014.920432, PMID 24865289.
Dludla SB, Mashabela LT, Ng’andwe B, Makoni PA, Witika BA. Current Advances in Nano-Based and Polymeric Stimuli-Responsive Drug Delivery Targeting the Ocular Microenvironment: a review and envisaged future perspectives. Polymers (Basel). 2022;14(17)3580. doi: 10.3390/polym14173580, PMID 36080651.
Khani S, Keyhanfar F, Amani A. Design and evaluation of oral nanoemulsion drug delivery system of mebudipine. Drug Deliv. 2016;23(6):2035-43. doi: 10.3109/10717544.2015.1088597, PMID 26406153.
Klang V, Matsko NB, Valenta C, Hofer F. Electron microscopy of nanoemulsions: an essential tool for characterisation and stability assessment. Micron. 2012;43(2-3):85-103. doi: 10.1016/j.micron.2011.07.014, PMID 21839644.
Anton N, Vandamme TF. Nanoemulsions and micro emulsions: clarifications of the critical differences. Pharm Res. 2011;28(5):978-85. doi: 10.1007/s11095-010-0309-1, PMID 21057856.
Vitorino C, Carvalho FA, Almeida AJ, Sousa JJ, Pais AA. The size of solid lipid nanoparticles: an interpretation from experimental design. Colloids Surf B Biointerfaces. 2011;84(1):117-30. doi: 10.1016/j.colsurfb.2010.12.024, PMID 21242064.
Rachmawati H, Budiputra DK, Mauludin R. Curcumin nanoemulsion for transdermal application: formulation and evaluation. Drug Dev Ind Pharm. 2015;41(4):560-6. doi: 10.3109/03639045.2014.884127, PMID 24502271.
Qian C, Mc Clements DJ. Formation of nanoemulsions stabilized by model food grade emulsifiers using high pressure homogenization: factors affecting particle size. Food Hydrocoll. 2011;25(5):1000-8. doi: 10.1016/j.foodhyd.2010.09.017.
Joseph D, K. Study on drug releasing behavior of different biopolymers. Indian Res J Pharm Sci. 2020;7(2):2227-50. doi: 10.21276/irjps.2020.7.2.15.
Sugumar S, Singh S, Mukherjee A, Chandrasekaran N. Nanoemulsion of orange oil with non ionic surfactant produced emulsion using ultrasonication technique: evaluating against food spoilage yeast. Appl Nanosci. 2016;6(1):113-20. doi: 10.1007/s13204-015-0412-z.
Alam T, Pandit J, Vohora D, Aqil M, Ali A, Sultana Y. Optimization of nanostructured lipid carriers of lamotrigine for brain delivery: in vitro characterization and in vivo efficacy in epilepsy. Expert Opin Drug Deliv. 2015;12(2):181-94. doi: 10.1517/17425247.2014.945416, PMID 25164097.
Sukre M, Barge V, Kasabe A, Shinde T, Kandge M. Formulation and evaluation of econazole nitrate microemulsion. Int J Health Sci. 2022;6(S3):9181-90. doi: 10.53730/ijhs.v6nS3.8243.
Kumar S, Patil A, Nile NP, Varma AK, Sahu D, Vishwakarma DK. Formulation and characterization of miconazole nanoemulgel for topical delivery by using natural oils. J Cardiovasc Dis Res. 2023;14(8):2166-82. doi: 10.1016/j.colsurfb.2013.07.043.
Musa SH, Basri M, Masoumi HR, Karjiban RA, Malek EA, Basri H. Formulation optimization of palm kernel oil esters nanoemulsion loaded with chloramphenicol suitable for meningitis treatment. Colloids Surf B Biointerfaces. 2013 Dec 1;112:113-19. doi: 10.1016/j.colsurfb.2013.07.043, PMID 23974000.
Alam T, Pandit J, Vohora D, Aqil M, Ali A, Sultana Y. Optimization of nanostructured lipid carriers of lamotrigine for brain delivery: in vitro characterization and in vivo efficacy in epilepsy. Expert Opin Drug Deliv. 2015;12(2):181-94. doi: 10.1517/17425247.2014.945416, PMID 25164097.